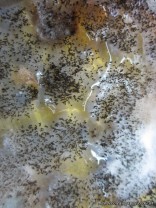
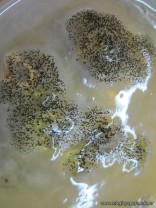
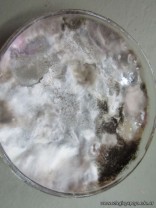

Los alumnos de 6to año, con orientación en Ciencias Naturales, en el espacio curricular Salud, realizaron en el laboratorio el cultivo de microorganismos; Previamente habian estudiado las noxas en general y habian abordado tecnicas de cultivo, tincion, así como también observacion macro y microscópica de bacterias y hongos.
Noticia anterior/siguiente:
Promoción de una Vida Saludable: Análisis de rótulos de Agua Mineral

Seguí al colegio